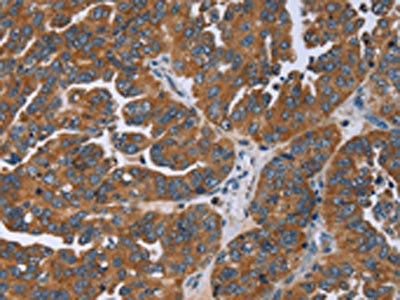

GAB2 Antibody
-
中文名稱:GAB2兔多克隆抗體
-
貨號:CSB-PA923404
-
規(guī)格:¥1100
-
圖片:
-
The image on the left is immunohistochemistry of paraffin-embedded Human ovarian cancer tissue using CSB-PA923404(GAB2 Antibody) at dilution 1/50, on the right is treated with fusion protein. (Original magnification: ×200)
-
The image on the left is immunohistochemistry of paraffin-embedded Human brain tissue using CSB-PA923404(GAB2 Antibody) at dilution 1/50, on the right is treated with fusion protein. (Original magnification: ×200)
-
Gel: 6%SDS-PAGE, Lysate: 40 μg, Lane 1-2: Hela cells, K562 cells, Primary antibody: CSB-PA923404(GAB2 Antibody) at dilution 1/300, Secondary antibody: Goat anti rabbit IgG at 1/8000 dilution, Exposure time: 3 minutes
-
-
其他:
產(chǎn)品詳情
-
Uniprot No.:
-
基因名:
-
別名:GAB 2 antibody; Gab2 antibody; GAB2_HUMAN antibody; Grb 2 associated binder 2 antibody; GRB 2 associated binding protein 2 antibody; Grb2 associated binder 2 antibody; GRB2 associated binder 2 pp100 antibody; GRB2 associated binding protein 2 antibody; GRB2-associated binder 2 antibody; GRB2-associated-binding protein 2 antibody; Growth factor receptor bound protein 2 associated protein 2 antibody; Growth factor receptor bound protein 2-associated protein 2 antibody; KIAA0571 antibody; p97 antibody; PH domain containing adaptor molecule p97 antibody; pp100 antibody
-
宿主:Rabbit
-
反應種屬:Human,Mouse,Rat
-
免疫原:Fusion protein of Human GAB2
-
免疫原種屬:Homo sapiens (Human)
-
標記方式:Non-conjugated
-
抗體亞型:IgG
-
純化方式:Antigen affinity purification
-
濃度:It differs from different batches. Please contact us to confirm it.
-
保存緩沖液:-20°C, pH7.4 PBS, 0.05% NaN3, 40% Glycerol
-
產(chǎn)品提供形式:Liquid
-
應用范圍:ELISA,WB,IHC
-
推薦稀釋比:
Application Recommended Dilution ELISA 1:2000-1:5000 WB 1:500-1:2000 IHC 1:50-1:200 -
Protocols:
-
儲存條件:Upon receipt, store at -20°C or -80°C. Avoid repeated freeze.
-
貨期:Basically, we can dispatch the products out in 1-3 working days after receiving your orders. Delivery time maybe differs from different purchasing way or location, please kindly consult your local distributors for specific delivery time.
-
用途:For Research Use Only. Not for use in diagnostic or therapeutic procedures.
相關產(chǎn)品
靶點詳情
-
功能:Adapter protein which acts downstream of several membrane receptors including cytokine, antigen, hormone, cell matrix and growth factor receptors to regulate multiple signaling pathways. Regulates osteoclast differentiation mediating the TNFRSF11A/RANK signaling. In allergic response, it plays a role in mast cells activation and degranulation through PI-3-kinase regulation. Also involved in the regulation of cell proliferation and hematopoiesis.
-
基因功能參考文獻:
- Alzheimer's Disease risk variant rs2373115 is associated with increased NARS2 expression in brain. GAB2 expression is increased in AD brain tissue. PMID: 30088171
- Knockdown of Gab2 suppressed the activity of both PI3K/AKT and MAPK/ERK pathways in HER2-overexpressing breast cancer cells. PMID: 30326469
- these findings demonstrate that miR-485 may play tumour suppressive roles in Colorectal cancer (CRC)by directly targeting GAB2 and indirectly regulating AKT and ERK signalling pathways, suggesting that miR-485 may be a potential therapeutic target for patients with this disease PMID: 29781037
- Gab2 is overexpressed in UMs and plays an important role in UM invasion. Moreover, our findings suggest a novel role for Gab2 in modulating MMP-2, MMP-9, and fascin expression in regulating the invasion of UM tumor cells PMID: 28791340
- a common locus (rs3740677) in 3' UTR of GAB2 sequence which is targeted by the miRNA-185 was explored the probable associations of rs3740677 with risk for late-onset AD (LOAD) in a large scale case-control study from Chinese Han populations. PMID: 27311772
- we provided evidences to imply that miR-302c-3p downregulation in human RCC cells causes Gab2 over-expression, Akt hyper-activation and cell proliferation. PMID: 28412750
- study identified that GAB2 as an adaptor protein was preferentially induced in Th2 differentiation and regulated Th2 immune responses PMID: 28477539
- The proto-oncogene GAB2 (11q14.1) was significantly amplified in non-smokers patients and GAB2 protein was relatively up-regulated in non-smoker than smoker tissues. GAB2 may represent a potential biomarker for lung SCC in non-smokers PMID: 28960030
- Results show that up-regulation of Gab2 expression was found to be positively correlated with VEGF in colorectal cancer (CRC) tissues, and suggest that Gab2 promotes intestinal tumor growth and angiogenesis through upregulation of VEGF expression mediated by the MEK/ERK/c-Myc pathway. PMID: 28420432
- The model showed agreement at several key nodes, involving scaffolding proteins Gab1, Gab2 and their complexes with Shp2. VEGFR2 recruitment of Gab1 is greater in magnitude, slower, and more sustained than that of Gab2. As Gab2 binds VEGFR2 complexes more transiently than Gab1, VEGFR2 complexes can recycle and continue to participate in other signaling pathways. PMID: 23805312
- The authors showed that GAB2 is cleaved at G238 during Coxsackievirus type B3 infection by viral proteinase 2A, generating two cleaved fragments of GAB2-N1-237 and GAB2-C238-676. PMID: 28361043
- Studied BAK1, SPRY4 and GAB2 SNPs in pediatric germ cell tumors(GCT); found a variant in SPRY4 was associated with reduced risk of GCT; a variant in BAK1 was positively associated with GCT with a strong estimated effect for testis tumors; and a SNP in GAB2 was associated with increased risk for GCT. PMID: 28295819
- overexpression of GAB2 in ovarian cancer cells promotes tumor growth and angiogenesis by upregulating expression of CXCL1, CXCL2 and CXCL8 that is IKKbeta-dependent. PMID: 26657155
- GAB2 is a key intermediary between YAP/TAZ and the PI3K/AKT pathway. PMID: 28202507
- The findings of this study suggested that GAB2 rs2373115 may contribute to Alzheimer's disease susceptibility only in European population but not in East Asian population. PMID: 28320126
- ERK1 and ERK2 interact with Gab2 via a novel docking motif, which is required for subsequent Gab2 phosphorylation in response to ERK1/2 activation. PMID: 28096188
- GAB2 is a functional downstream target of miR-302a in glioma. GAB2 role in cell proliferation, migration and invasion of glioma. PMID: 28000880
- overexpression of GAB2 suppressed the expression of miR197 in glioblastoma cells. PMID: 27035789
- GAB2 might promote hepatocellular carcinoma (HCC) cell proliferation by enhancing ERK signaling. PMID: 27026230
- Data indicate that the most prominent proteins associating with Gab2 are PTPN11, PIK3R1 and ARID3B. PMID: 27025927
- Study shows that Gab2 is significantly upregulated in metastasis-positive colorectal cancer (CRC) tissues and suggest that it plays a vital role in regulating CRC metastasis and a potential target for diagnosis. PMID: 26754532
- Grb2-associated binder 2 silencing impairs growth and migration of non-small cell lung cancer cells via PI3K-Akt signaling. PMID: 26617767
- Gab2 may be involved in the onset and progression of HCC, but its expression is unable to serve as an independent prognosis factor in HCC patients. PMID: 27544933
- miR125a-5p acting as a novel Gab2 suppressor is partly down- regulated by DNA hypermethylation in glioma PMID: 25598421
- GAB2, GSPT1, TFDP2 and ZFPM1 are four new susceptibility loci for testicular germ cell tumor. PMID: 26503584
- Data indicate that high-grade serous ovarian carcinoma (HGSC) cell lines with high GRB2 associated binding protein 2 (GAB2) expression are more responsive to phosphatidylinositol 3-kinases (PI3K) inhibitor PF-04691502. PMID: 25852062
- Gab2 expression may play an important role in the progression of colorectal carcinoma. PMID: 26045784
- In colorectal cancer, miR-125b mediates PAR2-induced cancer cell migration by targeting Gab2. PMID: 26354435
- Upregulations of Gab1 and Gab2 proteins associate with tumor progression of human gliomas. PMID: 24998422
- Down-regulation of Gab2 has a protective function during M. tuberculosis infection, revealing a potential negative regulatory role for Gab2 in immunity to TB. PMID: 24805943
- Gab2 protein expression was remarkably reduced in temporal neocortex of TLE patients PMID: 24327320
- High Gab2 expression is associated with glioma. PMID: 23231021
- GAB2 has a role as an ovarian cancer oncogene, trnasforming immortalized ovarian and fallopian tube secretory epithelial cells PMID: 24385586
- the GAB2 gene may be associated with sporadic Alzheimer's disease risk. PMID: 24161894
- Gab2 may protect neurons against late-onset Alzheimer's disease. PMID: 23724096
- interactions between the GAB2 and GSK3B polymorphisms and the well-established genetic factor APOE may modify the overall risk of Alzheimer disease. PMID: 23525328
- GAB2 is a novel regulator of tumor angiogenesis in NRAS-driven melanoma PMID: 22926523
- results indicate that RSK directly phosphorylates Gab2 on 3 serine residues; findings show RSK-mediated Gab2 phosphorylation inhibits Shp2 recruitment, suggesting RSK mediates a negative-feedback loop that attenuates Gab2-dependent functions including cell motility PMID: 23401857
- these data underscore the critical roles of Gab1 and Gab2 in IL-22-mediated HaCaT cell proliferation, migration, and differentiation. PMID: 22851227
- These results define a novel role for Gab2 in mediating mucin gene expression and GCH; these findings have important implications for the pathogenesis and therapy of airway inflammatory diseases. PMID: 22859374
- significant association between the GAB2 gene and morphological brain differences in 755 young adult twins.(GAB2) has been shown to provide a 1.27-1.51 increased odds of developing late Alzheimer's. PMID: 22856364
- Gab2 overexpression, via activation of the PI3K-Zeb1 pathway, promotes characteristics of epithelial-to-mesenchymal transition in ovarian cancer cells PMID: 21996746
- Our findings implicate an association between genetic variations of GAB2 and Alzheimer disease in Han Chinese PMID: 21285854
- Both phosphatidylinositol (PI)-3 kinase and SH2 domain-containing protein tyrosine phosphatase (SHP)2 binding sites of Gab2 are required for mast cell degranulation and the anaphylaxis response. PMID: 21653832
- over-expressed in malignant lung tissues PMID: 21552417
- Gab2 regulates cytoskeletal organization and cell motility by regulating RhoA activation and binding to Shp2. PMID: 21118992
- The findings implicate GAB2 as a susceptibility gene for late-onset Alzheimer disease in Han Chinese. PMID: 21108942
- this study supports the association between the possibly protective GAB2 haplotype and the risk of late-onset Alzheimer's disease in APOEepsilon4 carriers PMID: 20888920
- GAB2 rs2373115 polymorphism was not a remarkable factor in developing Alzheimer disease among Mongolian. PMID: 20188796
- findings indicate that while Gab2 expression is not prognostic in breast cancer, its role in early disease evolution warrants further analysis PMID: 20087860
顯示更多
收起更多
-
亞細胞定位:Cytoplasm. Cell membrane.
-
蛋白家族:GAB family
-
數(shù)據(jù)庫鏈接:
Most popular with customers
-
-
YWHAB Recombinant Monoclonal Antibody
Applications: ELISA, WB, IHC, IF, FC
Species Reactivity: Human, Mouse, Rat
-
Phospho-YAP1 (S127) Recombinant Monoclonal Antibody
Applications: ELISA, WB, IHC
Species Reactivity: Human
-
-
-
-
-